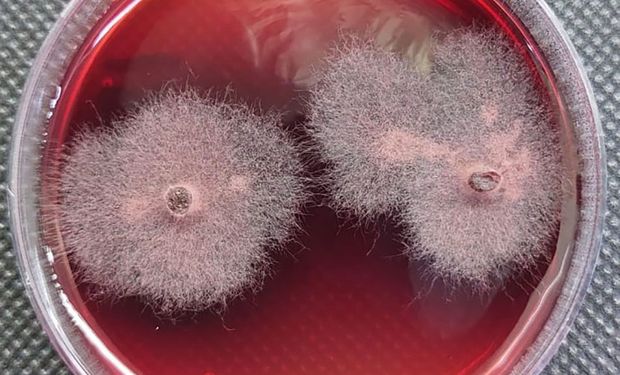
Embrapa descobre substância inédita para bioinsumos agrícolas

Embrapa descobre substância inédita para bioinsumos agrícolas
Descoberta mostrou eficiência superior contra fungos e plantas indesejadas, chegando a ter desempenho igual ou até melhor que alguns defensivos sintéticos
|
Pesquisadores da Embrapa, em parceria com a Universidade Federal de Minas Gerais (UFMG) e o Departamento de Agricultura dos EUA (USDA), identificaram uma substância inédita produzida por um fungo endofítico, um microrganismo que vive dentro dos tecidos vegetais sem causar danos, com forte potencial para uso em bioinsumos agrícolas.
O fungo isolado pertence ao gênero Piper, planta de relevância medicinal. Entre os metabólitos produzidos pelo fungo, há um composto novo, batizado provisoriamente de “composto 2”.
Em testes de laboratório, esse composto mostrou eficiência superior contra fungos e plantas indesejadas, chegando a ter desempenho igual ou até melhor que alguns defensivos sintéticos, como o glifosato e a clomazona.
“Esses microrganismos endofíticos são um reservatório promissor e ainda pouco explorado de metabólitos bioativos, capazes de gerar soluções inovadoras para a agricultura”, avalia Luiz Henrique Rosa, professor da UFMG.
O fungo estudado foi coletado no Parque Estadual da Floresta do Rio Doce (MG), em julho de 2017, e armazenado na Coleção de Micro-Organismos e Células da UFMG.